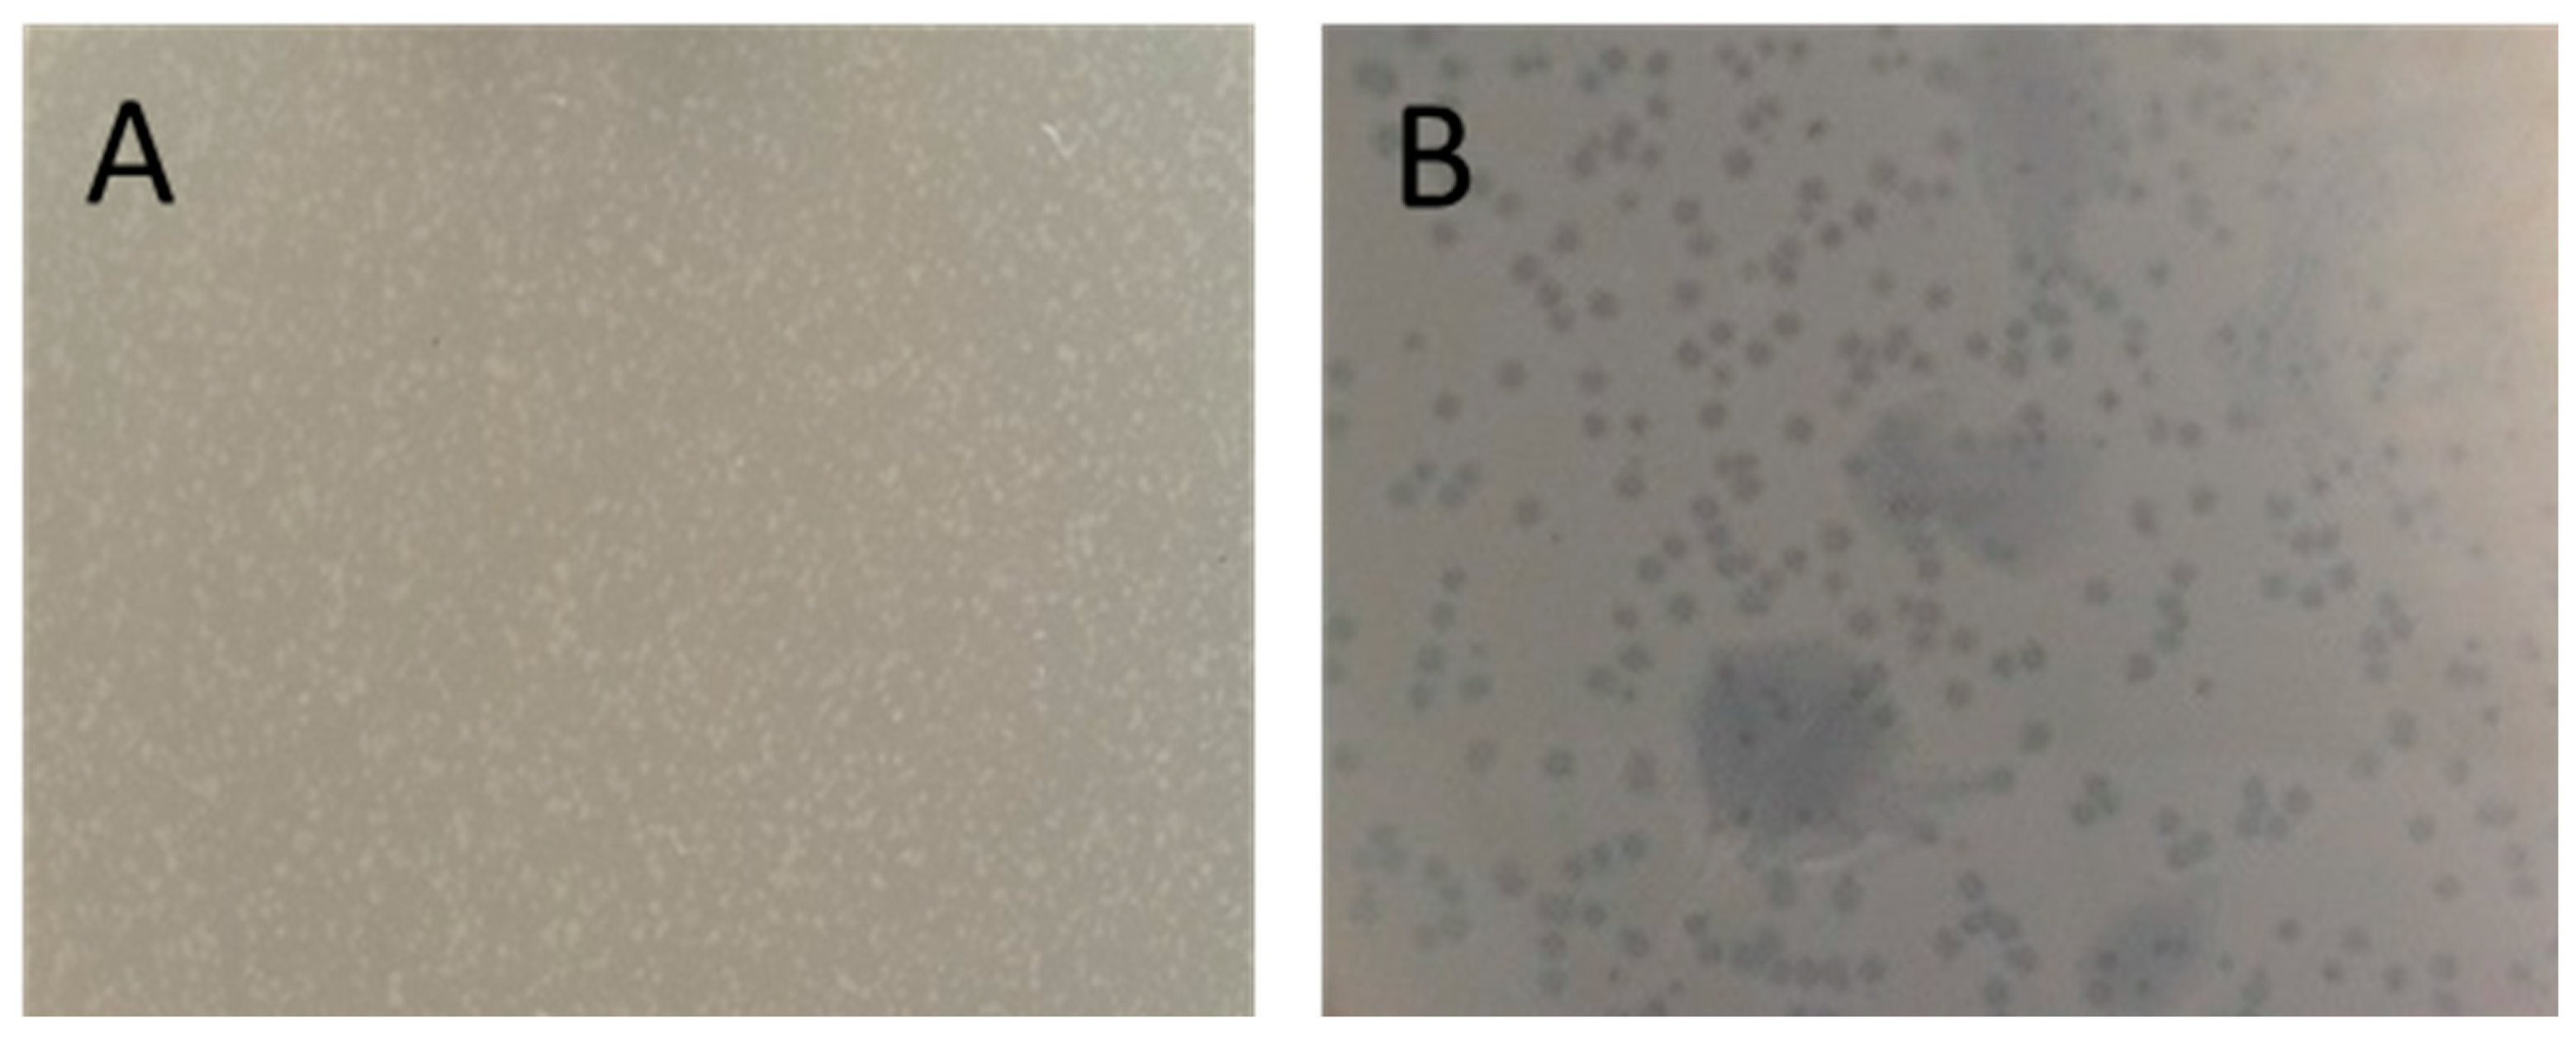
Antibiotics 13 00945 g004

Determinants of Antibiotic Resistance and Virulence Factors in the Genome of Escherichia coli APEC 36 Strain Isolated from a Broiler Chicken with Generalized Colibacillosis
Abstract
1. Introduction
2. Results
2.1. Genome Sequencing-Based General Characterization and Identification of E. coli Strain APEC 36
2.2. Genes and Potential Mechanisms of Antibiotic Resistance of E. coli Strain APEC 36
2.3. PCR Verification of the Presence of Virulence and Antibiotic Resistance Genes
2.4. Physiological Characteristics of E. coli Strain APEC 36
3. Discussion
4. Materials and Methods
4.1. Isolation and Identification of E. coli Strain APEC 36
4.2. Antibiotic Sensitivity Test
4.3. The Hemolysis Test
4.4. Iron Uptake Test
4.5. Lysogenic Phage Detection
4.6. Bacterial Adhesion to Red Blood Cells
4.7. Phylogenetic Group Determination
4.8. PCR Screening for Virulence and Beta-Lactamase Genes
4.9. Genomic DNA Isolation and Assessment of Its Quality and Quantity
4.10. DNA Library Preparation for Nanopore Sequencing
4.11. DNA Sequencing Using Nanopore Technology
4.12. Genome Assembly and Annotation
4.13. Phylogenetic Analysis
5. Conclusions
Supplementary Materials
Author Contributions
Funding
Institutional Review Board Statement
Informed Consent Statement
Data Availability Statement
Conflicts of Interest
References
- Antimicrobial Resistance, C. Global burden of bacterial antimicrobial resistance in 2019: A systematic analysis. Lancet 2022, 399, 629–655. [Google Scholar] [CrossRef]
- World Health Organization. Antimicrobial Resistance. Available online: https://www.who.int/news-room/fact-sheets/detail/antimicrobial-resistance (accessed on 7 August 2024).
- Yu, D.; Banting, G.; Neumann, N.F. A review of the taxonomy, genetics, and biology of the genus Escherichia and the type species Escherichia coli. Can. J. Microbiol. 2021, 67, 553–571. [Google Scholar] [CrossRef] [PubMed]
- Belanger, L.; Garenaux, A.; Harel, J.; Boulianne, M.; Nadeau, E.; Dozois, C.M. Escherichia coli from animal reservoirs as a potential source of human extraintestinal pathogenic E. coli. FEMS Immunol. Med. Microbiol. 2011, 62, 1–10. [Google Scholar] [CrossRef] [PubMed]
- Mora, A.; Viso, S.; Lopez, C.; Alonso, M.P.; Garcia-Garrote, F.; Dabhi, G.; Mamani, R.; Herrera, A.; Marzoa, J.; Blanco, M.; et al. Poultry as reservoir for extraintestinal pathogenic Escherichia coli O45:K1:H7-B2-ST95 in humans. Vet. Microbiol. 2013, 167, 506–512. [Google Scholar] [CrossRef] [PubMed]
- Manges, A.R. Escherichia coli and urinary tract infections: The role of poultry-meat. Clin. Microbiol. Infect. 2016, 22, 122–129. [Google Scholar] [CrossRef]
- Mageiros, L.; Meric, G.; Bayliss, S.C.; Pensar, J.; Pascoe, B.; Mourkas, E.; Calland, J.K.; Yahara, K.; Murray, S.; Wilkinson, T.S.; et al. Genome evolution and the emergence of pathogenicity in avian Escherichia coli. Nat. Commun. 2021, 12, 765. [Google Scholar] [CrossRef]
- Sora, V.M.; Meroni, G.; Martino, P.A.; Soggiu, A.; Bonizzi, L.; Zecconi, A. Extraintestinal Pathogenic Escherichia coli: Virulence Factors and Antibiotic Resistance. Pathogens 2021, 10, 1355. [Google Scholar] [CrossRef]
- Jalil, A.; Gul, S.; Bhatti, M.F.; Siddiqui, M.F.; Adnan, F. High Occurrence of Multidrug-Resistant Escherichia coli Strains in Bovine Fecal Samples from Healthy Cows Serves as Rich Reservoir for AMR Transmission. Antibiotics 2022, 12, 37. [Google Scholar] [CrossRef]
- Stanley, D.; Batacan, R., Jr.; Bajagai, Y.S. Rapid growth of antimicrobial resistance: The role of agriculture in the problem and the solutions. Appl. Microbiol. Biotechnol. 2022, 106, 6953–6962. [Google Scholar] [CrossRef]
- Santos, A.C.M.; Santos, F.F.; Silva, R.M.; Gomes, T.A.T. Diversity of Hybrid- and Hetero-Pathogenic Escherichia coli and Their Potential Implication in More Severe Diseases. Front. Cell. Infect. Microbiol. 2020, 10, 339. [Google Scholar] [CrossRef]
- Cao, H.; Bougouffa, S.; Park, T.J.; Lau, A.; Tong, M.K.; Chow, K.H.; Ho, P.L. Sharing of Antimicrobial Resistance Genes between Humans and Food Animals. mSystems 2022, 7, e0077522. [Google Scholar] [CrossRef] [PubMed]
- Xin, H.; Gao, M.; Wang, X.; Qiu, T.; Guo, Y.; Zhang, L. Animal farms are hot spots for airborne antimicrobial resistance. Sci. Total Environ. 2022, 851, 158050. [Google Scholar] [CrossRef]
- Fatoba, D.O.; Amoako, D.G.; Abia, A.L.K.; Essack, S.Y. Transmission of Antibiotic-Resistant Escherichia coli from Chicken Litter to Agricultural Soil. Front. Environ. Sci. 2022, 9, 751732. [Google Scholar] [CrossRef]
- Djordjevic, S.P.; Jarocki, V.M.; Seemann, T.; Cummins, M.L.; Watt, A.E.; Drigo, B.; Wyrsch, E.R.; Reid, C.J.; Donner, E.; Howden, B.P. Genomic surveillance for antimicrobial resistance—A One Health perspective. Nat. Rev. Genet. 2024, 25, 142–157. [Google Scholar] [CrossRef] [PubMed]
- Gurevich, A.; Saveliev, V.; Vyahhi, N.; Tesler, G. QUAST: Quality assessment tool for genome assemblies. Bioinformatics 2013, 29, 1072–1075. [Google Scholar] [CrossRef] [PubMed]
- Simao, F.A.; Waterhouse, R.M.; Ioannidis, P.; Kriventseva, E.V.; Zdobnov, E.M. BUSCO: Assessing genome assembly and annotation completeness with single-copy orthologs. Bioinformatics 2015, 31, 3210–3212. [Google Scholar] [CrossRef] [PubMed]
- Rodriguez, R.L.; Gunturu, S.; Harvey, W.T.; Rossello-Mora, R.; Tiedje, J.M.; Cole, J.R.; Konstantinidis, K.T. The Microbial Genomes Atlas (MiGA) webserver: Taxonomic and gene diversity analysis of Archaea and Bacteria at the whole genome level. Nucleic Acids Res. 2018, 46, W282–W288. [Google Scholar] [CrossRef]
- Seemann, T. Prokka: Rapid prokaryotic genome annotation. Bioinformatics 2014, 30, 2068–2069. [Google Scholar] [CrossRef]
- Brettin, T.; Davis, J.J.; Disz, T.; Edwards, R.A.; Gerdes, S.; Olsen, G.J.; Olson, R.; Overbeek, R.; Parrello, B.; Pusch, G.D.; et al. RASTtk: A modular and extensible implementation of the RAST algorithm for building custom annotation pipelines and annotating batches of genomes. Sci. Rep. 2015, 5, 8365. [Google Scholar] [CrossRef]
- Jolley, K.A.; Bray, J.E.; Maiden, M.C.J. Open-access bacterial population genomics: BIGSdb software, the PubMLST.org website and their applications. Wellcome Open Res. 2018, 3, 124. [Google Scholar] [CrossRef]
- Olson, R.D.; Assaf, R.; Brettin, T.; Conrad, N.; Cucinell, C.; Davis, J.J.; Dempsey, D.M.; Dickerman, A.; Dietrich, E.M.; Kenyon, R.W.; et al. Introducing the Bacterial and Viral Bioinformatics Resource Center (BV-BRC): A resource combining PATRIC, IRD and ViPR. Nucleic Acids Res. 2023, 51, D678–D689. [Google Scholar] [CrossRef] [PubMed]
- Kailasan Vanaja, S.; Bergholz, T.M.; Whittam, T.S. Characterization of the Escherichia coli O157:H7 Sakai GadE regulon. J. Bacteriol. 2009, 191, 1868–1877. [Google Scholar] [CrossRef] [PubMed]
- Gambushe, S.M.; Zishiri, O.T.; El Zowalaty, M.E. Review of Escherichia coli O157:H7 Prevalence, Pathogenicity, Heavy Metal and Antimicrobial Resistance, African Perspective. Infect. Drug Resist. 2022, 15, 4645–4673. [Google Scholar] [CrossRef] [PubMed]
- Carattoli, A.; Hasman, H. PlasmidFinder and In Silico pMLST: Identification and Typing of Plasmid Replicons in Whole-Genome Sequencing (WGS). Methods Mol. Biol. 2020, 2075, 285–294. [Google Scholar] [CrossRef]
- Payne, L.J.; Meaden, S.; Mestre, M.R.; Palmer, C.; Toro, N.; Fineran, P.C.; Jackson, S.A. PADLOC: A web server for the identification of antiviral defence systems in microbial genomes. Nucleic Acids Res. 2022, 50, W541–W550. [Google Scholar] [CrossRef]
- Alcock, B.P.; Huynh, W.; Chalil, R.; Smith, K.W.; Raphenya, A.R.; Wlodarski, M.A.; Edalatmand, A.; Petkau, A.; Syed, S.A.; Tsang, K.K.; et al. CARD 2023: Expanded curation, support for machine learning, and resistome prediction at the Comprehensive Antibiotic Resistance Database. Nucleic Acids Res. 2023, 51, D690–D699. [Google Scholar] [CrossRef]
- Saier, M.H.; Reddy, V.S.; Moreno-Hagelsieb, G.; Hendargo, K.J.; Zhang, Y.; Iddamsetty, V.; Lam, K.J.K.; Tian, N.; Russum, S.; Wang, J.; et al. The Transporter Classification Database (TCDB): 2021 update. Nucleic Acids Res. 2021, 49, D461–D467. [Google Scholar] [CrossRef]
- Mao, C.; Abraham, D.; Wattam, A.R.; Wilson, M.J.; Shukla, M.; Yoo, H.S.; Sobral, B.W. Curation, integration and visualization of bacterial virulence factors in PATRIC. Bioinformatics 2015, 31, 252–258. [Google Scholar] [CrossRef]
- Wishart, D.S.; Feunang, Y.D.; Guo, A.C.; Lo, E.J.; Marcu, A.; Grant, J.R.; Sajed, T.; Johnson, D.; Li, C.; Sayeeda, Z.; et al. DrugBank 5.0: A major update to the DrugBank database for 2018. Nucleic Acids Res. 2018, 46, D1074–D1082. [Google Scholar] [CrossRef]
- Alcock, B.P.; Raphenya, A.R.; Lau, T.T.Y.; Tsang, K.K.; Bouchard, M.; Edalatmand, A.; Huynh, W.; Nguyen, A.V.; Cheng, A.A.; Liu, S.; et al. CARD 2020: Antibiotic resistome surveillance with the comprehensive antibiotic resistance database. Nucleic Acids Res. 2020, 48, D517–D525. [Google Scholar] [CrossRef]
- Yang, X.; Ye, W.; Qi, Y.; Ying, Y.; Xia, Z. Overcoming Multidrug Resistance in Bacteria Through Antibiotics Delivery in Surface-Engineered Nano-Cargos: Recent Developments for Future Nano-Antibiotics. Front. Bioeng. Biotechnol. 2021, 9, 696514. [Google Scholar] [CrossRef] [PubMed]
- Du, D.; Wang-Kan, X.; Neuberger, A.; van Veen, H.W.; Pos, K.M.; Piddock, L.J.V.; Luisi, B.F. Multidrug efflux pumps: Structure, function and regulation. Nat. Rev. Microbiol. 2018, 16, 523–539. [Google Scholar] [CrossRef] [PubMed]
- Horiyama, T.; Nishino, K. AcrB, AcrD, and MdtABC multidrug efflux systems are involved in enterobactin export in Escherichia coli. PLoS ONE 2014, 9, e108642. [Google Scholar] [CrossRef] [PubMed]
- Anes, J.; McCusker, M.P.; Fanning, S.; Martins, M. The ins and outs of RND efflux pumps in Escherichia coli. Front. Microbiol. 2015, 6, 587. [Google Scholar] [CrossRef] [PubMed]
- Andersen, J.L.; He, G.-X.; Kakarla, P.; KC, R.; Kumar, S.; Lakra, W.S.; Mukherjee, M.M.; Ranaweera, I.; Shrestha, U.; Tran, T.; et al. Multidrug efflux pumps from Enterobacteriaceae, Vibrio cholerae and Staphylococcus aureus bacterial food pathogens. Int. J. Environ. Res. Public Health 2015, 12, 1487–1547. [Google Scholar] [CrossRef]
- Moller, T.S.; Overgaard, M.; Nielsen, S.S.; Bortolaia, V.; Sommer, M.O.; Guardabassi, L.; Olsen, J.E. Relation between tetR and tetA expression in tetracycline resistant Escherichia coli. BMC Microbiol. 2016, 16, 39. [Google Scholar] [CrossRef]
- Slipski, C.J.; Zhanel, G.G.; Bay, D.C. Biocide Selective TolC-Independent Efflux Pumps in Enterobacteriaceae. J. Membr. Biol. 2018, 251, 15–33. [Google Scholar] [CrossRef]
- Srinivasan, V.B.; Rajamohan, G. KpnEF, a new member of the Klebsiella pneumoniae cell envelope stress response regulon, is an SMR-type efflux pump involved in broad-spectrum antimicrobial resistance. Antimicrob. Agents Chemother. 2013, 57, 4449–4462. [Google Scholar] [CrossRef]
- Cao, Y.; Peng, Q.; Li, S.; Deng, Z.; Gao, J. The intriguing biology and chemistry of fosfomycin: The only marketed phosphonate antibiotic. RSC Adv. 2019, 9, 42204–42218. [Google Scholar] [CrossRef]
- Takahata, S.; Ida, T.; Hiraishi, T.; Sakakibara, S.; Maebashi, K.; Terada, S.; Muratani, T.; Matsumoto, T.; Nakahama, C.; Tomono, K. Molecular mechanisms of fosfomycin resistance in clinical isolates of Escherichia coli. Int. J. Antimicrob. Agents 2010, 35, 333–337. [Google Scholar] [CrossRef]
- Rossbach, S.; Kunze, K.; Albert, S.; Zehner, S.; Gottfert, M. The Sinorhizobium meliloti EmrAB efflux system is regulated by flavonoids through a TetR-like regulator (EmrR). Mol. Plant-Microbe Interact. 2014, 27, 379–387. [Google Scholar] [CrossRef] [PubMed]
- Hirakawa, H.; Takumi-Kobayashi, A.; Theisen, U.; Hirata, T.; Nishino, K.; Yamaguchi, A. AcrS/EnvR represses expression of the acrAB multidrug efflux genes in Escherichia coli. J. Bacteriol. 2008, 190, 6276–6279. [Google Scholar] [CrossRef] [PubMed]
- Subhadra, B.; Kim, J.; Kim, D.H.; Woo, K.; Oh, M.H.; Choi, C.H. Local Repressor AcrR Regulates AcrAB Efflux Pump Required for Biofilm Formation and Virulence in Acinetobacter nosocomialis. Front. Cell. Infect. Microbiol. 2018, 8, 270. [Google Scholar] [CrossRef] [PubMed]
- Praski Alzrigat, L.; Huseby, D.L.; Brandis, G.; Hughes, D. Resistance/fitness trade-off is a barrier to the evolution of MarR inactivation mutants in Escherichia coli. J. Antimicrob. Chemother. 2021, 76, 77–83. [Google Scholar] [CrossRef]
- Vinue, L.; Hooper, D.C.; Jacoby, G.A. Chromosomal mutations that accompany qnr in clinical isolates of Escherichia coli. Int. J. Antimicrob. Agents 2018, 51, 479–483. [Google Scholar] [CrossRef]
- Alekshun, M.N.; Kim, Y.S.; Levy, S.B. Mutational analysis of MarR, the negative regulator of marRAB expression in Escherichia coli, suggests the presence of two regions required for DNA binding. Mol. Microbiol. 2000, 35, 1394–1404. [Google Scholar] [CrossRef]
- Shimada, T.; Yamamoto, K.; Ishihama, A. Involvement of the leucine response transcription factor LeuO in regulation of the genes for sulfa drug efflux. J. Bacteriol. 2009, 191, 4562–4571. [Google Scholar] [CrossRef]
- Shimada, T.; Bridier, A.; Briandet, R.; Ishihama, A. Novel roles of LeuO in transcription regulation of E. coli genome: Antagonistic interplay with the universal silencer H-NS. Mol. Microbiol. 2011, 82, 378–397. [Google Scholar] [CrossRef]
- Nishino, K.; Yamaguchi, A. Overexpression of the response regulator evgA of the two-component signal transduction system modulates multidrug resistance conferred by multidrug resistance transporters. J. Bacteriol. 2001, 183, 1455–1458. [Google Scholar] [CrossRef]
- Pomposiello, P.J.; Demple, B. Redox-operated genetic switches: The SoxR and OxyR transcription factors. Trends Biotechnol. 2001, 19, 109–114. [Google Scholar] [CrossRef]
- Aly, S.A.; Boothe, D.M.; Suh, S.J. A novel alanine to serine substitution mutation in SoxS induces overexpression of efflux pumps and contributes to multidrug resistance in clinical Escherichia coli isolates. J. Antimicrob. Chemother. 2015, 70, 2228–2233. [Google Scholar] [CrossRef] [PubMed]
- Misawa, K.; Tarumoto, N.; Tamura, S.; Osa, M.; Hamamoto, T.; Yuki, A.; Kouzaki, Y.; Imai, K.; Ronald, R.L.; Yamaguchi, T.; et al. Single nucleotide polymorphisms in genes encoding penicillin-binding proteins in beta-lactamase-negative ampicillin-resistant Haemophilus influenzae in Japan. BMC Res. Notes 2018, 11, 53. [Google Scholar] [CrossRef] [PubMed]
- Prezioso, S.M.; Brown, N.E.; Goldberg, J.B. Elfamycins: Inhibitors of elongation factor-Tu. Mol. Microbiol. 2017, 106, 22–34. [Google Scholar] [CrossRef] [PubMed]
- Zeef, L.A.; Bosch, L.; Anborgh, P.H.; Cetin, R.; Parmeggiani, A.; Hilgenfeld, R. Pulvomycin-resistant mutants of E. coli elongation factor Tu. EMBO J. 1994, 13, 5113–5120. [Google Scholar] [CrossRef] [PubMed]
- Philippon, A.; Arlet, G.; Labia, R.; Iorga, B.I. Class C beta-Lactamases: Molecular Characteristics. Clin. Microbiol. Rev. 2022, 35, e0015021. [Google Scholar] [CrossRef]
- Zarate, S.G.; De la Cruz Claure, M.L.; Benito-Arenas, R.; Revuelta, J.; Santana, A.G.; Bastida, A. Overcoming Aminoglycoside Enzymatic Resistance: Design of Novel Antibiotics and Inhibitors. Molecules 2018, 23, 284. [Google Scholar] [CrossRef]
- Ramirez, M.S.; Tolmasky, M.E. Aminoglycoside modifying enzymes. Drug Resist. Updat. 2010, 13, 151–171. [Google Scholar] [CrossRef]
- Takahashi, Y.; Igarashi, M. Destination of aminoglycoside antibiotics in the ‘post-antibiotic era’. J. Antibiot. 2017, 71, 4–14. [Google Scholar] [CrossRef]
- Ghafoori, S.M.; Robles, A.M.; Arada, A.M.; Shirmast, P.; Dranow, D.M.; Mayclin, S.J.; Lorimer, D.D.; Myler, P.J.; Edwards, T.E.; Kuhn, M.L.; et al. Structural characterization of a Type B chloramphenicol acetyltransferase from the emerging pathogen Elizabethkingia anophelis NUHP1. Sci. Rep. 2021, 11, 9453. [Google Scholar] [CrossRef]
- Franck, E.; Crofts, T.S. History of the streptothricin antibiotics and evidence for the neglect of the streptothricin resistome. npj Antimicrob. Resist. 2024, 2, 3. [Google Scholar] [CrossRef]
- Harbottle, J.; Mosaei, H.; Allenby, N.; Zenkin, N. Kanglemycin A Can Overcome Rifamycin Resistance Caused by ADP-Ribosylation by Arr Protein. Antimicrob. Agents Chemother. 2021, 65, e0086421. [Google Scholar] [CrossRef] [PubMed]
- Venkatesan, M.; Fruci, M.; Verellen, L.A.; Skarina, T.; Mesa, N.; Flick, R.; Pham, C.; Mahadevan, R.; Stogios, P.J.; Savchenko, A. Molecular mechanism of plasmid-borne resistance to sulfonamide antibiotics. Nat. Commun. 2023, 14, 4031. [Google Scholar] [CrossRef] [PubMed]
- He, J.; Qiao, W.; An, Q.; Yang, T.; Luo, Y. Dihydrofolate reductase inhibitors for use as antimicrobial agents. Eur. J. Med. Chem. 2020, 195, 112268. [Google Scholar] [CrossRef] [PubMed]
- Miranda, C.D.; Concha, C.; Godoy, F.A.; Lee, M.R. Aquatic Environments as Hotspots of Transferable Low-Level Quinolone Resistance and Their Potential Contribution to High-Level Quinolone Resistance. Antibiotics 2022, 11, 1487. [Google Scholar] [CrossRef]
- Borzi, M.M.; Cardozo, M.V.; Oliveira, E.S.; Pollo, A.S.; Guastalli, E.A.L.; Santos, L.F.D.; Avila, F.A. Characterization of avian pathogenic Escherichia coli isolated from free-range helmeted guineafowl. Braz. J. Microbiol. 2018, 49 (Suppl. S1), 107–112. [Google Scholar] [CrossRef]
- Logue, C.M.; Wannemuehler, Y.; Nicholson, B.A.; Doetkott, C.; Barbieri, N.L.; Nolan, L.K. Comparative Analysis of Phylogenetic Assignment of Human and Avian ExPEC and Fecal Commensal Escherichia coli Using the (Previous and Revised) Clermont Phylogenetic Typing Methods and its Impact on Avian Pathogenic Escherichia coli (APEC) Classification. Front. Microbiol. 2017, 8, 283. [Google Scholar] [CrossRef]
- Oliveira, E.S.; Cardozo, M.V.; Borzi, M.M.; Borges, C.A.; Guastalli, E.A.L.; Ávila, F.A. Highly Pathogenic and Multidrug Resistant Avian Pathogenic Escherichia coli in Free-Range Chickens from Brazil. Braz. J. Poult. Sci. 2019, 21, eRBCA-2019-0876. [Google Scholar] [CrossRef]
- van Overbeek, L.S.; Wichers, J.H.; van Amerongen, A.; van Roermund, H.J.W.; van der Zouwen, P.; Willemsen, P.T.J. Circulation of Shiga Toxin-Producing Escherichia coli Phylogenetic Group B1 Strains Between Calve Stable Manure and Pasture Land With Grazing Heifers. Front. Microbiol. 2020, 11, 1355. [Google Scholar] [CrossRef]
- Cheng, R.; Huang, F.; Wu, H.; Lu, X.; Yan, Y.; Yu, B.; Wang, X.; Zhu, B. A nucleotide-sensing endonuclease from the Gabija bacterial defense system. Nucleic Acids Res. 2021, 49, 5216–5229. [Google Scholar] [CrossRef]
- Stokar-Avihail, A.; Fedorenko, T.; Hor, J.; Garb, J.; Leavitt, A.; Millman, A.; Shulman, G.; Wojtania, N.; Melamed, S.; Amitai, G.; et al. Discovery of phage determinants that confer sensitivity to bacterial immune systems. Cell 2023, 186, 1863–1876.e16. [Google Scholar] [CrossRef]
- Shaw, L.P.; Rocha, E.P.C.; MacLean, R.C. Restriction-modification systems have shaped the evolution and distribution of plasmids across bacteria. Nucleic Acids Res. 2023, 51, 6806–6818. [Google Scholar] [CrossRef] [PubMed]
- Mamontov, V.; Martynov, A.; Morozova, N.; Bukatin, A.; Staroverov, D.B.; Lukyanov, K.A.; Ispolatov, Y.; Semenova, E.; Severinov, K. Persistence of plasmids targeted by CRISPR interference in bacterial populations. Proc. Natl. Acad. Sci. USA 2022, 119, e2114905119. [Google Scholar] [CrossRef] [PubMed]
- Zhao, S.; Maurer, J.J.; Hubert, S.; De Villena, J.F.; McDermott, P.F.; Meng, J.; Ayers, S.; English, L.; White, D.G. Antimicrobial susceptibility and molecular characterization of avian pathogenic Escherichia coli isolates. Vet. Microbiol. 2005, 107, 215–224. [Google Scholar] [CrossRef] [PubMed]
- Koga, V.L.; Rodrigues, G.R.; Scandorieiro, S.; Vespero, E.C.; Oba, A.; de Brito, B.G.; de Brito, K.C.; Nakazato, G.; Kobayashi, R.K. Evaluation of the Antibiotic Resistance and Virulence of Escherichia coli Strains Isolated from Chicken Carcasses in 2007 and 2013 from Parana, Brazil. Foodborne Pathog. Dis. 2015, 12, 479–485. [Google Scholar] [CrossRef]
- Wibisono, F.J.; Effendi, M.H.; Wibisono, F.M. Occurrence, antimicrobial resistance, and potential zoonosis risk of avian pathogenic Escherichia coli in Indonesia: A review. Int. J. One Health 2022, 8, 76–85. [Google Scholar] [CrossRef]
- Boulianne, M.; Arsenault, J.; Daignault, D.; Archambault, M.; Letellier, A.; Dutil, L. Drug use and antimicrobial resistance among Escherichia coli and Enterococcus spp. isolates from chicken and turkey flocks slaughtered in Quebec, Canada. Can. J. Vet. Res. 2016, 80, 49–59. [Google Scholar]
- Hiki, M.; Kawanishi, M.; Abo, H.; Kojima, A.; Koike, R.; Hamamoto, S.; Asai, T. Decreased Resistance to Broad-Spectrum Cephalosporin in Escherichia coli from Healthy Broilers at Farms in Japan After Voluntary Withdrawal of Ceftiofur. Foodborne Pathog. Dis. 2015, 12, 639–643. [Google Scholar] [CrossRef]
- Shrestha, R.D.; Agunos, A.; Gow, S.P.; Deckert, A.E.; Varga, C. Associations between antimicrobial resistance in fecal Escherichia coli isolates and antimicrobial use in Canadian turkey flocks. Front. Microbiol. 2022, 13, 954123. [Google Scholar] [CrossRef]
- U.S. Food and Drug Administration. CVM GFI #213 New Animal Drugs and New Animal Drug Combination Products Administered in or on Medicated Feed or Drinking Water of Food-Producing Animals: Recommendations for Drug Sponsors for Voluntarily Aligning Product Use Conditions with GFI #209. Available online: https://www.fda.gov/regulatory-information/search-fda-guidance-documents/cvm-gfi-213-new-animal-drugs-and-new-animal-drug-combination-products-administered-or-medicated-feed (accessed on 21 August 2024).
- Bean-Hodgins, L.; Kiarie, E.G. Mandated restrictions on the use of medically important antibiotics in broiler chicken production in Canada: Implications, emerging challenges, and opportunities for bolstering gastrointestinal function and health—A review. Can. J. Anim. Sci. 2021, 101, 602–629. [Google Scholar] [CrossRef]
- Hedman, H.D.; Vasco, K.A.; Zhang, L. A Review of Antimicrobial Resistance in Poultry Farming within Low-Resource Settings. Animals 2020, 10, 1264. [Google Scholar] [CrossRef]
- Schmerold, I.; van Geijlswijk, I.; Gehring, R. European regulations on the use of antibiotics in veterinary medicine. Eur. J. Pharm. Sci. 2023, 189, 106473. [Google Scholar] [CrossRef] [PubMed]
- Shchepetkina, S.V. Antibiotics in poultry farming: To prohibit cannot be rationed. Effic. Livest. Breed. 2019, 4, 80–84. [Google Scholar] [CrossRef]
- Koo, M.S.; Lee, J.H.; Rah, S.Y.; Yeo, W.S.; Lee, J.W.; Lee, K.L.; Koh, Y.S.; Kang, S.O.; Roe, J.H. A reducing system of the superoxide sensor SoxR in Escherichia coli. EMBO J. 2003, 22, 2614–2622. [Google Scholar] [CrossRef] [PubMed]
- Li, Z.; Demple, B. SoxS, an activator of superoxide stress genes in Escherichia coli. Purification and interaction with DNA. J. Biol. Chem. 1994, 269, 18371–18377. [Google Scholar] [CrossRef]
- Koutsolioutsou, A.; Pena-Llopis, S.; Demple, B. Constitutive soxR mutations contribute to multiple-antibiotic resistance in clinical Escherichia coli isolates. Antimicrob. Agents Chemother. 2005, 49, 2746–2752. [Google Scholar] [CrossRef]
- Martin, R.G.; Rosner, J.L. Binding of purified multiple antibiotic-resistance repressor protein (MarR) to mar operator sequences. Proc. Natl. Acad. Sci. USA 1995, 92, 5456–5460. [Google Scholar] [CrossRef]
- Alekshun, M.N.; Levy, S.B. Alteration of the repressor activity of MarR, the negative regulator of the Escherichia coli marRAB locus, by multiple chemicals in vitro. J. Bacteriol. 1999, 181, 4669–4672. [Google Scholar] [CrossRef]
- Martin, R.G.; Jair, K.W.; Wolf, R.E., Jr.; Rosner, J.L. Autoactivation of the marRAB multiple antibiotic resistance operon by the MarA transcriptional activator in Escherichia coli. J. Bacteriol. 1996, 178, 2216–2223. [Google Scholar] [CrossRef][Green Version]
- Du, D.; Wang, Z.; James, N.R.; Voss, J.E.; Klimont, E.; Ohene-Agyei, T.; Venter, H.; Chiu, W.; Luisi, B.F. Structure of the AcrAB-TolC multidrug efflux pump. Nature 2014, 509, 512–515. [Google Scholar] [CrossRef]
- Ma, D.; Alberti, M.; Lynch, C.; Nikaido, H.; Hearst, J.E. The local repressor AcrR plays a modulating role in the regulation of acrAB genes of Escherichia coli by global stress signals. Mol. Microbiol. 1996, 19, 101–112. [Google Scholar] [CrossRef]
- Geng, H.; Jiang, R. cAMP receptor protein (CRP)-mediated resistance/tolerance in bacteria: Mechanism and utilization in biotechnology. Appl. Microbiol. Biotechnol. 2015, 99, 4533–4543. [Google Scholar] [CrossRef] [PubMed]
- Tramonti, A.; Visca, P.; De Canio, M.; Falconi, M.; De Biase, D. Functional characterization and regulation of gadX, a gene encoding an AraC/XylS-like transcriptional activator of the Escherichia coli glutamic acid decarboxylase system. J. Bacteriol. 2002, 184, 2603–2613. [Google Scholar] [CrossRef] [PubMed]
- Nishino, K.; Senda, Y.; Yamaguchi, A. The AraC-family regulator GadX enhances multidrug resistance in Escherichia coli by activating expression of mdtEF multidrug efflux genes. J. Infect. Chemother. 2008, 14, 23–29. [Google Scholar] [CrossRef] [PubMed]
- Dorman, C.J. H-NS: A universal regulator for a dynamic genome. Nat. Rev. Microbiol. 2004, 2, 391–400. [Google Scholar] [CrossRef] [PubMed]
- Marden, J.N.; Diaz, M.R.; Walton, W.G.; Gode, C.J.; Betts, L.; Urbanowski, M.L.; Redinbo, M.R.; Yahr, T.L.; Wolfgang, M.C. An unusual CsrA family member operates in series with RsmA to amplify posttranscriptional responses in Pseudomonas aeruginosa. Proc. Natl. Acad. Sci. USA 2013, 110, 15055–15060. [Google Scholar] [CrossRef] [PubMed]
- Kato, A.; Ohnishi, H.; Yamamoto, K.; Furuta, E.; Tanabe, H.; Utsumi, R. Transcription of emrKY is regulated by the EvgA-EvgS two-component system in Escherichia coli K-12. Biosci. Biotechnol. Biochem. 2000, 64, 1203–1209. [Google Scholar] [CrossRef]
- Law, C.J.; Alegre, K.O. Clamping down on drugs: The Escherichia coli multidrug efflux protein MdtM. Res. Microbiol. 2018, 169, 461–467. [Google Scholar] [CrossRef]
- Zhang, Y.; Xiao, M.; Horiyama, T.; Zhang, Y.; Li, X.; Nishino, K.; Yan, A. The multidrug efflux pump MdtEF protects against nitrosative damage during the anaerobic respiration in Escherichia coli. J. Biol. Chem. 2011, 286, 26576–26584. [Google Scholar] [CrossRef]
- Li, X.Z.; Nikaido, H. Efflux-mediated drug resistance in bacteria: An update. Drugs 2009, 69, 1555–1623. [Google Scholar] [CrossRef]
- Lomovskaya, O.; Lewis, K.; Matin, A. EmrR is a negative regulator of the Escherichia coli multidrug resistance pump EmrAB. J. Bacteriol. 1995, 177, 2328–2334. [Google Scholar] [CrossRef]
- Tavio, M.M.; Jacoby, G.A.; Hooper, D.C. QnrS1 structure-activity relationships. J. Antimicrob. Chemother. 2014, 69, 2102–2109. [Google Scholar] [CrossRef] [PubMed]
- Juraschek, K.; Kasbohrer, A.; Malorny, B.; Schwarz, S.; Meemken, D.; Hammerl, J.A. Dissection of Highly Prevalent qnrS1-Carrying IncX Plasmid Types in Commensal Escherichia coli from German Food and Livestock. Antibiotics 2021, 10, 1236. [Google Scholar] [CrossRef] [PubMed]
- Nasrollahian, S.; Graham, J.P.; Halaji, M. A review of the mechanisms that confer antibiotic resistance in pathotypes of E. coli. Front. Cell. Infect. Microbiol. 2024, 14, 1387497. [Google Scholar] [CrossRef] [PubMed]
- Papouskova, A.; Masarikova, M.; Valcek, A.; Senk, D.; Cejkova, D.; Jahodarova, E.; Cizek, A. Genomic analysis of Escherichia coli strains isolated from diseased chicken in the Czech Republic. BMC Vet. Res. 2020, 16, 189. [Google Scholar] [CrossRef]
- Sun, S.; Selmer, M.; Andersson, D.I. Resistance to beta-lactam antibiotics conferred by point mutations in penicillin-binding proteins PBP3, PBP4 and PBP6 in Salmonella enterica. PLoS ONE 2014, 9, e97202. [Google Scholar] [CrossRef]
- Hossain, M.K.; Rahman, M.; Nahar, A.; Khair, A.; Alam, M.M. Isolation and identification of diarrheagenic Escherichia coli causing colibacillosis in calf in selective areas of Bangladesh. Bangl. J. Vet. Med. 2013, 11, 145–149. [Google Scholar] [CrossRef]
- Alexander, D.B.; Zuberer, D.A. Use of chrome azurol S reagents to evaluate siderophore production by rhizosphere bacteria. Biol. Fertil. Soils 1991, 12, 39–45. [Google Scholar] [CrossRef]
- Brilis, V.I.; Brilene, T.A.; Lentsner Kh, P.; Lentsner, A.A. Method of studying the adhesive process of microorganisms. Lab. Delo 1986, 4, 210–212. [Google Scholar]
- Clermont, O.; Christenson, J.K.; Denamur, E.; Gordon, D.M. The Clermont Escherichia coli phylo-typing method revisited: Improvement of specificity and detection of new phylo-groups. Environ. Microbiol. Rep. 2013, 5, 58–65. [Google Scholar] [CrossRef]
- Chapman, T.A.; Wu, X.Y.; Barchia, I.; Bettelheim, K.A.; Driesen, S.; Trott, D.; Wilson, M.; Chin, J.J. Comparison of virulence gene profiles of Escherichia coli strains isolated from healthy and diarrheic swine. Appl. Environ. Microbiol. 2006, 72, 4782–4795. [Google Scholar] [CrossRef]
- Kuhar, I.; Grabnar, M.; Zgur-Bertok, D. Virulence determinants of uropathogenic Escherichia coli in fecal strains from intestinal infections and healthy individuals. FEMS Microbiol. Lett. 1998, 164, 243–248. [Google Scholar] [CrossRef] [PubMed]
- Kerenyi, M.; Allison, H.E.; Batai, I.; Sonnevend, A.; Emody, L.; Plaveczky, N.; Pal, T. Occurrence of hlyA and sheA genes in extraintestinal Escherichia coli strains. J. Clin. Microbiol. 2005, 43, 2965–2968. [Google Scholar] [CrossRef] [PubMed]
- Moulin-Schouleur, M.; Reperant, M.; Laurent, S.; Bree, A.; Mignon-Grasteau, S.; Germon, P.; Rasschaert, D.; Schouler, C. Extraintestinal pathogenic Escherichia coli strains of avian and human origin: Link between phylogenetic relationships and common virulence patterns. J. Clin. Microbiol. 2007, 45, 3366–3376. [Google Scholar] [CrossRef]
- Johnson, J.R.; Stell, A.L. Extended virulence genotypes of Escherichia coli strains from patients with urosepsis in relation to phylogeny and host compromise. J. Infect. Dis. 2000, 181, 261–272. [Google Scholar] [CrossRef] [PubMed]
- Guiral, E.; Bosch, J.; Vila, J.; Soto, S.M. Prevalence of Escherichia coli among samples collected from the genital tract in pregnant and nonpregnant women: Relationship with virulence. FEMS Microbiol. Lett. 2011, 314, 170–173. [Google Scholar] [CrossRef] [PubMed]
- Ulett, G.C.; Valle, J.; Beloin, C.; Sherlock, O.; Ghigo, J.M.; Schembri, M.A. Functional analysis of antigen 43 in uropathogenic Escherichia coli reveals a role in long-term persistence in the urinary tract. Infect. Immun. 2007, 75, 3233–3244. [Google Scholar] [CrossRef] [PubMed]
- Le Bouguenec, C.; Archambaud, M.; Labigne, A. Rapid and specific detection of the pap, afa, and sfa adhesin-encoding operons in uropathogenic Escherichia coli strains by polymerase chain reaction. J. Clin. Microbiol. 1992, 30, 1189–1193. [Google Scholar] [CrossRef]
- Johnson, T.J.; Wannemuehler, Y.; Doetkott, C.; Johnson, S.J.; Rosenberger, S.C.; Nolan, L.K. Identification of minimal predictors of avian pathogenic Escherichia coli virulence for use as a rapid diagnostic tool. J. Clin. Microbiol. 2008, 46, 3987–3996. [Google Scholar] [CrossRef] [PubMed]
- Subedi, M.; Luitel, H.; Devkota, B.; Bhattarai, R.K.; Phuyal, S.; Panthi, P.; Shrestha, A.; Chaudhary, D.K. Antibiotic resistance pattern and virulence genes content in avian pathogenic Escherichia coli (APEC) from broiler chickens in Chitwan, Nepal. BMC Vet. Res. 2018, 14, 113. [Google Scholar] [CrossRef]
- Nakano, M.; Yamamoto, S.; Terai, A.; Ogawa, O.; Makino, S.I.; Hayashi, H.; Nair, G.B.; Kurazono, H. Structural and sequence diversity of the pathogenicity island of uropathogenic Escherichia coli which encodes the USP protein. FEMS Microbiol. Lett. 2001, 205, 71–76. [Google Scholar] [CrossRef]
- O’Hara, R.W.; Jenks, P.J.; Emery, M.; Upton, M. Rapid detection of extra-intestinal pathogenic Escherichia coli multi-locus sequence type 127 using a specific PCR assay. J. Med. Microbiol. 2019, 68, 188–196. [Google Scholar] [CrossRef] [PubMed]
- Poirel, L.; Naas, T.; Le Thomas, I.; Karim, A.; Bingen, E.; Nordmann, P. CTX-M-type extended-spectrum beta-lactamase that hydrolyzes ceftazidime through a single amino acid substitution in the omega loop. Antimicrob. Agents Chemother. 2001, 45, 3355–3361. [Google Scholar] [CrossRef] [PubMed]
- Kotsakis, S.D.; Flach, C.F.; Razavi, M.; Larsson, D.G.J. Characterization of the First OXA-10 Natural Variant with Increased Carbapenemase Activity. Antimicrob. Agents Chemother. 2019, 63, e01817-18. [Google Scholar] [CrossRef] [PubMed]
- Colom, K.; Perez, J.; Alonso, R.; Fernandez-Aranguiz, A.; Larino, E.; Cisterna, R. Simple and reliable multiplex PCR assay for detection of blaTEM, bla(SHV) and blaOXA-1 genes in Enterobacteriaceae. FEMS Microbiol. Lett. 2003, 223, 147–151. [Google Scholar] [CrossRef] [PubMed]
- Kolmogorov, M.; Yuan, J.; Lin, Y.; Pevzner, P.A. Assembly of long, error-prone reads using repeat graphs. Nat. Biotechnol. 2019, 37, 540–546. [Google Scholar] [CrossRef]
- Ondov, B.D.; Treangen, T.J.; Melsted, P.; Mallonee, A.B.; Bergman, N.H.; Koren, S.; Phillippy, A.M. Mash: Fast genome and metagenome distance estimation using MinHash. Genome Biol. 2016, 17, 132. [Google Scholar] [CrossRef]
- Davis, J.J.; Gerdes, S.; Olsen, G.J.; Olson, R.; Pusch, G.D.; Shukla, M.; Vonstein, V.; Wattam, A.R.; Yoo, H. PATtyFams: Protein Families for the Microbial Genomes in the PATRIC Database. Front. Microbiol. 2016, 7, 118. [Google Scholar] [CrossRef]
- Edgar, R.C. MUSCLE: Multiple sequence alignment with high accuracy and high throughput. Nucleic Acids Res. 2004, 32, 1792–1797. [Google Scholar] [CrossRef]
- Stamatakis, A. RAxML version 8: A tool for phylogenetic analysis and post-analysis of large phylogenies. Bioinformatics 2014, 30, 1312–1313. [Google Scholar] [CrossRef]
- Stamatakis, A.; Hoover, P.; Rougemont, J. A rapid bootstrap algorithm for the RAxML Web servers. Syst. Biol. 2008, 57, 758–771. [Google Scholar] [CrossRef]

| Gene | adk | fumC | gyrB | icd | mdh | purA | recA |
|---|---|---|---|---|---|---|---|
| Allele | 10 | 11 | 4 | 12 | 8 | 18 | 2 |
| Plasmid | Identity | Contig | Contig Length, bp | Position in Contig |
|---|---|---|---|---|
| Col(MG828) | 95.79 | Contig 1 | 1209 | 434…694 |
| IncX1 | 98.4 | Contig 2 | 54,843 | 23,254…23,627 |
| p0111 | 98.64 | Contig 6 | 75,049 | 29,044…29,928 |
| IncI1-I(Alpha) | 99.3 | Contig 8 | 108,625 | 70,271…70,412 |
| Functional Group of Genes | Database | Number of Genes |
|---|---|---|
| Victors | 2 | |
| Associated with antibiotic resistance | CARD | 95 |
| NDARO | 21 | |
| PATRIC | 71 | |
| Encoding drug targets | DrugBank | 383 |
| TTD | 59 | |
| Transporter genes | TCDB | 889 |
| Virulence factor genes | PATRIC_VF | 203 |
| VFDB | 48 | |
| Victors | 212 |
| Gene (ARO Accession Number of the Reference Gene) | Gene Family | Class of Antibiotics | Mechanism of Resistance | Match with Reference Gene % |
|---|---|---|---|---|
| aac(3)-IId (3004623) | AAC(3) | Aminoglycosides | Antibiotic inactivation | 100 |
| aadA (3002602) | ANT(3″) | Aminoglycosides | Antibiotic inactivation | 99.62 |
| acrA (3000207) | RND (resistance-nodulation-cell division) antibiotic efflux pumps | Fluoroquinolones, cephalosporins, glycylcycline antibiotics, penicillins, tetracyclines, rifampicin, amphenicols, disinfecting compounds and antiseptics | Antibiotic efflux | 100 |
| acrB (3000216) | RND antibiotic efflux pumps | Fluoroquinolones, cephalosporins, glycylcycline antibiotics, penicillins, tetracyclines, rifampicin, amphenicols, disinfecting compounds and antiseptics | Antibiotic efflux | 100 |
| acrD (3000491) | RND antibiotic efflux pumps | Aminoglycosides | Antibiotic efflux | 99.9 |
| acrE (3000499) | RND antibiotic efflux pumps | Fluoroquinolones, cephalosporins, cefamycin, penicillins | Antibiotic efflux | 100 |
| acrF (3000502) | RND antibiotic efflux pumps | Fluoroquinolones, cephalosporins, cefamycin, penicillins | Antibiotic efflux | 99.71 |
| acrS (3000656) | Transcriptional regulator of RND antibiotic efflux pumps | Fluoroquinolones, cephalosporins, glycylcycline antibiotics, cefamycin, penicillins, tetracyclines, rifampicin, amphenicols, disinfecting compounds and antiseptics | Antibiotic efflux | 100 |
| ampC (3004290) | AmpC-type β-lactamase | Cephalosporins, penicillins | Antibiotic inactivation | 98.14 |
| arnT (3005053) | Phosphoethanolamine transferase | Peptide antibiotics | Target modification | 63.52 |
| arr-2 (3002847) | Rifampin ADP-ribosyltransferase | Rifampicin | Antibiotic inactivation | 100 |
| bacA (3002986) | Proteins that are associated with undecaprenyl pyrophosphate | Peptide antibiotics | Target modification | 100 |
| baeR (3000828) | Transcriptional regulator of RND antibiotic efflux pumps | Aminoglycosides, aminocoumarin antibiotics | Antibiotic efflux | 96.23 |
| catIII (3002685) | Chloramphenicol acetyltransferase | Amphenicols | Antibiotic inactivation | 99.53 |
| cmlA5 (3002695) | MFS (major facilitator superfamily) antibiotic efflux pumps | Amphenicols | Antibiotic efflux | 100 |
| cpxA (3000830) | Transcriptional regulator of RND antibiotic efflux pumps | Aminoglycosides, aminocoumarin antibiotics | Antibiotic efflux | 100 |
| crp (3000518) | Encodes CRP transcriptional regulator of RND antibiotic efflux pumps | Macrolides, fluoroquinolones, penicillins | Antibiotic efflux | 99.52 |
| blaCTX-M-169 (3005592) | CTX-M β-lactamase | Cephalosporins | Antibiotic inactivation | 100 |
| dfrA14 (3002859) | Trimethoprim-resistant dihydrofolate reductase | Diaminopyrimidines | Target substitution | 100 |
| tufA (3003369) | Encodes EF-Tu resistant to elphamycin | Elphamycins | Target modification | 99.75 |
| emrA (3000027) | MFS antibiotic efflux pumps | Fluoroquinolones | Antibiotic efflux | 99.74 |
| emrB (3000074) | MFS antibiotic efflux pumps | Fluoroquinolones | Antibiotic efflux | 100 |
| emrK (3000206) | MFS antibiotic efflux pumps | Tetracyclines | Antibiotic efflux | 100 |
| emrR (3000516) | MFS antibiotic efflux pumps | Fluoroquinolones | Antibiotic efflux | 100 |
| emrY (3000254) | MFS antibiotic efflux pumps | Tetracyclines | Antibiotic efflux | 99.41 |
| eptA (3003576) | Phosphoethanolamine transferase | Peptide antibiotics | Target modification | 99.82 |
| evgA (3000832) | Transcriptional regulator of MFS antibiotic efflux pumps, RND antibiotic efflux pumps | Macrolides, fluoroquinolones, penicillins, tetracyclines | Antibiotic efflux | 100 |
| evgS (3000833) | Transcriptional regulator of MFS antibiotic efflux pumps, RND antibiotic efflux pumps | Macrolides, fluoroquinolones, penicillins, tetracyclines | Antibiotic efflux | 99.58 |
| gadX (3000508) | Transcriptional regulator of RND antibiotic efflux pumps | Macrolides, fluoroquinolones, penicillins | Antibiotic efflux | 100 |
| glpT (3003889) | GlpT resistant to antibiotics | Phosphonic acid derivatives | Target modification | 99.78 |
| hns (3000676) | Encodes H-NS transcriptional regulator of MFS and RND antibiotic efflux pumps | Macrolides, fluoroquinolones, cephalosporins, cefamycin, penicillins, tetracyclines | Antibiotic efflux | 100 |
| kdpE (3003841) | Transcriptional regulator of kdpDE two-component regulatory system | Aminoglycosides | Antibiotic efflux | 100 |
| kpnE (3004580) | SMR (small multidrug resistance) antibiotic efflux pumps | Macrolides, aminoglycosides, cephalosporins, tetracyclines, peptide antibiotics, rifampicin, disinfecting compounds and antiseptics | Antibiotic efflux | 82.2 |
| kpnF (3004583) | SMR antibiotic efflux pumps | Macrolides, aminoglycosides, cephalosporins, tetracyclines, peptide antibiotics, rifampicin, disinfecting compounds and antiseptics | Antibiotic efflux | 84.4 |
| leuO (3003843) | Transcriptional regulator of MFS antibiotic efflux pumps | Nucleoside antibiotics, disinfecting compounds and antiseptics | Antibiotic efflux | 99.04 |
| marA (3000263) | Transcriptional regulator of RND antibiotic efflux pumps and porin with reduced permeability to β-lactams | Fluoroquinolones, monobactams, carbapenems, cephalosporins, glycylcycline antibiotics, cefamycin, penicillins, tetracyclines, rifampicin, amphenicols, penems, disinfecting compounds and antiseptics | Antibiotic efflux, cell wall permeability reduction | 100 |
| mdfA (3001328) | MFS antibiotic efflux pumps | Tetracyclines, disinfecting compounds and antiseptics | Antibiotic efflux | 97.07 |
| mdtA (3000792) | RND antibiotic efflux pumps | Aminocoumarin antibiotics | Antibiotic efflux | 99.04 |
| mdtB (3000793) | RND antibiotic efflux pumps | Aminocoumarin antibiotics | Antibiotic efflux | 99.81 |
| mdtC (3000794) | RND antibiotic efflux pumps | Aminocoumarin antibiotics | Antibiotic efflux | 99.9 |
| mdtE (3000795) | RND antibiotic efflux pumps | Macrolides, fluoroquinolones, penicillins | Antibiotic efflux | 100 |
| mdtF (3000796) | RND antibiotic efflux pumps | Macrolides, fluoroquinolones, penicillins | Antibiotic efflux | 99.9 |
| mdtG (3001329) | MFS antibiotic efflux pumps | Phosphonic acid derivatives | Antibiotic efflux | 100 |
| mdtH (3001216) | MFS antibiotic efflux pumps | Fluoroquinolones | Antibiotic efflux | 99.75 |
| mdtM (3001214) | MFS antibiotic efflux pumps | Fluoroquinolones, lincosamide antibiotics, nucleoside antibiotics, amphenicols, disinfecting compounds and antiseptics | Antibiotic efflux | 98.01 |
| mdtN (3003548) | MFS antibiotic efflux pumps | Nucleoside antibiotics, disinfecting compounds and antiseptics | Antibiotic efflux | 99.71 |
| mdtO (3003549) | MFS antibiotic efflux pumps | Nucleoside antibiotics, disinfecting compounds and antiseptics | Antibiotic efflux | 100 |
| mdtP (3003550) | MFS antibiotic efflux pumps | Nucleoside antibiotics, disinfecting compounds and antiseptics | Antibiotic efflux | 98.36 |
| msbA (3003950) | ABC (ATP-binding cassette) antibiotic efflux pumps | Nitroimidazoles | Antibiotic efflux | 100 |
| blaOXA-10 (3001405) | OXA β-lactamase, similar to OXA-10 | Cephalosporins, penicillins | Antibiotic inactivation | 100 |
| ftsI (pbpB) (3004446) | Penicillin-binding proteins conferring resistance to β-lactam antibiotics | Cephalosporins, cefamycin, penicillins | Target modification | 53.11 |
| pmrF (3003578) | Phosphoethanolamine transferase | Peptide antibiotics | Target modification | 100 |
| qacL (3005098) | SMR antibiotic efflux pumps | Disinfecting compounds and antiseptics | Antibiotic efflux | 93.64 |
| qnrS1 (3002790) | Quinolone resistance proteins | Fluoroquinolones | Protection of the antibiotic target | 100 |
| rsmA (3005069) | RND antibiotic efflux pumps | Fluoroquinolones, diaminopyrimidines, amphenicols | Antibiotic efflux | 85.25 |
| sat2 (3002895) | Streptothricin acetyltransferase | Nucleoside antibiotics | Antibiotic inactivation | 100 |
| soxR (3000836) | Transcriptional regulator of ABC, MFS, and RND antibiotic efflux pumps | Fluoroquinolones, cephalosporins, glycylcycline antibiotics, penicillins, tetracyclines, rifampicin, amphenicols, disinfecting compounds and antiseptics | Target modification, antibiotic efflux | 100 |
| soxS (3000837) | Transcriptional regulator of ABC, MFS, and RND antibiotic efflux pumps and porin with reduced permeability to β-lactams | Fluoroquinolones, monobactams, carbapenems, cephalosporins, glycylcycline antibiotics, cefamycin, penicillins, tetracyclines, rifampicin, amphenicols, penems, disinfecting compounds and antiseptics | Target modification, antibiotic efflux, cell wall permeability reduction | 100 |
| sul2 (3000412) | Sulfonamide resistance | Sulfonamides | Target substitution | 100 |
| sul3 (3000413) | Sulfonamide resistance | Sulfonamides | Target substitution | 100 |
| blaTEM-1 (3000873) | TEM β-lactamase | Monobactams, cephalosporins, penicillins, penems | Antibiotic inactivation | 100 |
| tet(A) (3000165) | MFS antibiotic efflux pumps | Tetracyclines | Antibiotic efflux | 99.74 |
| tolC (3000237) | ABC antibiotic efflux pumps, MFS antibiotic efflux pumps, RND antibiotic efflux pumps | Macrolides, fluoroquinolones, aminoglycosides, carbapenems, cephalosporins, glycylcycline antibiotics, cefamycin, penicillins, tetracyclines, peptide antibiotics, aminocoumarin antibiotics, rifampicin, amphenicols, penems, disinfecting compounds and antiseptics | Antibiotic efflux | 100 |
| vanG (3002909) | Glycopeptide resistance gene cluster, ligase Van | Glycopeptide antibiotics | Target modification | 38.23 |
| yojI (3003952) | ABC antibiotic efflux pumps | Peptide antibiotics | Antibiotic efflux | 99.82 |
| Functional Group of Genes | Gene | Detected by PCR |
|---|---|---|
| Toxins | east1 | + |
| ehxA | − | |
| eltA | + | |
| estI | + | |
| estII | − | |
| cnf1 | − | |
| hlyA | − | |
| hlyF | + | |
| stx1 | − | |
| stx2 | − | |
| Adhesins | afa/draBC | − |
| iha | + | |
| fimH | + | |
| flu | − | |
| papC | − | |
| sfaDE | − | |
| Protectins | iss | − |
| kpsMTII | + | |
| ompT | − | |
| Iron uptake system | iroN | + |
| iutA | + | |
| UPEC-specific proteins | usp | − |
| upaG | + | |
| Beta-lactamases | blaCTX-M | + |
| blaOXA | + | |
| blaSHV | − | |
| blaTEM | + |
| Antibiotic Group | Antibiotic | Growth Inhibition Zone Diameter (mm) | Sensitivity (S)/Resistance (R) | Putative Genome-Encoded Determinants of Resistance |
|---|---|---|---|---|
| Penicillins | Ampicillin | <14 | R | AcrAB-TolC, AcrR, AcrEFS, AmpC, CRP, EvgAS, GadX, H-NS, MarRA, MdtEF, OXA-10, PBP3, SoxRS, TEM-1 |
| Amoxicillin/clavulanic acid | <19 | S | ||
| Cephalosporins | Cefuroxime | <19 | R | AcrAB-TolC, AcrR, AcrEFS, AmpC, CTX-M-169, H-NS, KpnEF, MarRA, OXA-10, PBP3, SoxRS, TEM-1 |
| Cefotaxime | <17 | R | ||
| Cefixime | <17 | R | ||
| Ceftazidime | <19 | S | ||
| Cefepime | <24 | S | ||
| Carbapenems | Meropenem | <15 | S | MarA, SoxS, TolC |
| Aminoglycosides | Gentamicin | <14 | S | AAC(3)-IId, AadA, ArcD, BaeR, CpxA, KdpE, KpnEF, TolC |
| Amikacin | <15 | S | ||
| Fluoroquinolones | Ciprofloxacin | <24 | R | AcrAB-TolC, AcrR, AcrEFS, CRP, EmrRAB, EvgAS, GadX, H-NS, MarRA, MdtEFHM, QnrS1, RsmA, SoxRS |
| Levofloxacin | <19 | R | ||
| Tetracyclines | Tetracycline | <12 | R | AcrAB-TolC, AcrR, AcrS, MarRA, EmrKY, EvgAS, H-NS, KpnEF, MdfA, SoxRS, Tet(A) |
| Trimethoprim/ sulfonamides | Cotrimoxazole | <11 | R | Sul2, Sul3 |
| Amphenicols | Chloramphenicol | <17 | R | AcrAB-TolC, AcrR, MarRA, AcrS, CatIII, CmlA5, MdtM, RsmA, SoxRS |
| Gene | Oligonucleotide Name and Sequences (5′->3′) | Amplicon Size, bp | Source |
|---|---|---|---|
| east1 | east 11a: CCATCAACACAGTATATCCGA east 11b: GGTCGCGAGTGACGGCTTTGT | 111 | [112] |
| ehxA | ehxA-F: GCATCATCAAGCGTACGTTCC ehxA-R: AATGAGCCAAGCTGGTTAAGCT | 534 | [112] |
| eltA | LTA-1: GGCGACAGATTATACCGTGC LTA-2: CCGAATTCTGTTATATATGTC | 696 | [112] |
| estI | STa1: TCTTTCCCCTCTTTTAGTCAG STa2: ACAGGCAGGATTACAACAAAG | 166 | [112] |
| estII | STb-1: ATCGCATTTCTTCTTGCATC STb-2: GGGCGCCAAAGCATGCTCC | 172 | [112] |
| cnf1 | CNF1-1: CTGACTTGCCGTGGTTTAGTCGG CNF1-2: TACACTATTGACATGCTGCCCGGA | 1295 | [113] |
| hlyA | hlyA1: GTCTGCAAAGCAATCCGCTGCAAATAAA hlyA2: CTGTGTCCACGAGTTGGTTGATTAG | 561 | [114] |
| hlyF | hlyF1: TCGTTTAGGGTGCTTACCTTCAAC hlyF2: TTTGGCGGTTTAGGCATTCC | 444 | [115] |
| stx1 | stx1-F: ATAAATCGCCTATCGTTGACTAC stx1-R: AGAACGCCCACTGAGATCATC | 180 | [112] |
| stx2 | stx2-F: GGCACTGTCTGAAACTGCTCC stx2-R: TCGCCAGTTATCTGACATTCTG | 255 | [112] |
| afa/draBC | afa/draBC-F: GGCAGAGGGCCGGCAACAGGC afa/draBC-R: CCCGTAACGCGCCAGCATCTC | 592 | [116] |
| iha | IHA-F: CTGGCGGAGGCTCTGAGATCA IHA-R: TCCTTAAGCTCCCGCGGCTGA | 827 | [112] |
| fimH | FimH1: CAGCGATGATTTCCAGTTTGTGTG FimH2: TGCGTACCAGCATTAGCAATGTCC | 461 | [117] |
| flu | flu-F: GGGTAAAGCTGATAATGTCG flu-R: GTTGCTGACAGTGAGTGTGC | 508 | [118] |
| papC | Pap1: GACGGCTGTACTGCAGGGTGTGGCG Pap2: ATATCCTTTCTGCAGGGATGCAATA | 328 | [119] |
| sfaDE | SFA-1: CTCCGGAGAACTGGGTGCATCTTAC SFA-2: CGGAGGAGTAATTACAAACCTGGCA | 410 | [119] |
| iss | iss-F: CAGCAACCCGAACCACTTGATG iss-R: AGCATTGCCAGAGCGGCAGAA | 323 | [112] |
| kpsMTII | kpsMT_II f: GCGCATTTGCTGATACTGTTG kpsMT_II r: CATCCAGACGATAAGCATGAGCA | 270 | [116] |
| ompT | ompT-F: TCATCCCGGAAGCCTCCCTCACTACTAT ompT-R: TAGCGTTTGCTGCACTGGCTTCTGATAC | 496 | [120] |
| iroN | iroN f: AAGTCAAAGCAGGGGTTGCCCG iroN r: GACGCCGACATTAAGACGCAG | 925 | [116] |
| iutA | iutA-F: GGCTGGACATCATGGGAACTGG iutA-R: CGTCGGGAACGGGTAGAATCG | 301 | [121] |
| usp | USP-N6: ATGCTACTGTTTCCGGGTAGTGTGT USP-N7: CATCATGTAGTCGGGGCGTAACAAT | 1017 | [122] |
| upaG | upaG-F: GATAGGCAAGGACGCAAGA upaG-R: GGTCGCAATATCCGTAGT | 1218 | [123] |
| blaCTX-M | CTX-M-A: CGCTTTGCGATGTGCAG CTX-M-B: ACCGCGATATCGTTGGT | 551 | [124] |
| blaOXA | OXA-10-F: GGCGAAAAAGTAAACCTC OXA-10-R: CAGTAAATCCTGCGCTAC | 568 | [125] |
| blaSHV | SHV-F: AGGATTGACTGCCTTTTTG SHV-R: ATTTGCTGATTTCGCTCG | 392 | [126] |
| blaTEM | TEM-C: ATCAGCAATAAACCAGC TEM-H: CCCCGAAGAACGTTTTC | 516 | [126] |
Disclaimer/Publisher’s Note: The statements, opinions and data contained in all publications are solely those of the individual author(s) and contributor(s) and not of MDPI and/or the editor(s). MDPI and/or the editor(s) disclaim responsibility for any injury to people or property resulting from any ideas, methods, instructions or products referred to in the content. |
© 2024 by the authors. Licensee MDPI, Basel, Switzerland. This article is an open access article distributed under the terms and conditions of the Creative Commons Attribution (CC BY) license (https://creativecommons.org/licenses/by/4.0/).
Share and Cite
Karpov, D.S.; Kazakova, E.M.; Kovalev, M.A.; Shumkov, M.S.; Kusainova, T.; Tarasova, I.A.; Osipova, P.J.; Poddubko, S.V.; Mitkevich, V.A.; Kuznetsova, M.V.; et al. Determinants of Antibiotic Resistance and Virulence Factors in the Genome of Escherichia coli APEC 36 Strain Isolated from a Broiler Chicken with Generalized Colibacillosis. Antibiotics 2024, 13, 945. https://doi.org/10.3390/antibiotics13100945
Karpov DS, Kazakova EM, Kovalev MA, Shumkov MS, Kusainova T, Tarasova IA, Osipova PJ, Poddubko SV, Mitkevich VA, Kuznetsova MV, et al. Determinants of Antibiotic Resistance and Virulence Factors in the Genome of Escherichia coli APEC 36 Strain Isolated from a Broiler Chicken with Generalized Colibacillosis. Antibiotics. 2024; 13(10):945. https://doi.org/10.3390/antibiotics13100945
Chicago/Turabian StyleKarpov, Dmitry S., Elizaveta M. Kazakova, Maxim A. Kovalev, Mikhail S. Shumkov, Tomiris Kusainova, Irina A. Tarasova, Pamila J. Osipova, Svetlana V. Poddubko, Vladimir A. Mitkevich, Marina V. Kuznetsova, and et al. 2024. "Determinants of Antibiotic Resistance and Virulence Factors in the Genome of Escherichia coli APEC 36 Strain Isolated from a Broiler Chicken with Generalized Colibacillosis" Antibiotics 13, no. 10: 945. https://doi.org/10.3390/antibiotics13100945
APA StyleKarpov, D. S., Kazakova, E. M., Kovalev, M. A., Shumkov, M. S., Kusainova, T., Tarasova, I. A., Osipova, P. J., Poddubko, S. V., Mitkevich, V. A., Kuznetsova, M. V., & Goncharenko, A. V. (2024). Determinants of Antibiotic Resistance and Virulence Factors in the Genome of Escherichia coli APEC 36 Strain Isolated from a Broiler Chicken with Generalized Colibacillosis. Antibiotics, 13(10), 945. https://doi.org/10.3390/antibiotics13100945

